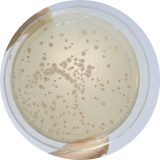
Microbianas

Cervicitis
Causas, síntomas y tratamiento
Datos claves
Aproximadamente del 15% al 20% de mujeres con síntomas de herpes genital presentan cervicitis.
La clamidia es la causa más común de la cervicitis.
Se estima que del 10% al 20% de mujeres infectadas con clamidia presentan síntomas de cervicitis.
La infección genital por herpes simple no tratada puede causar cervicitis.
Tan solo en la Ciudad de México, la prevalencia de la clamidia va desde el 1.5% al 28.9%.
El papanicolau tiene una efectividad del 79.1% a 90% en la detección del cáncer de cuello uterino.
El cáncer del cuello uterino es la 2da causa de muerte por cáncer en las mujeres mexicanas.
9 doctores ofrecen tratamiento para cervicitis en doctoranytime.
¿Qué es la cervicitis?
La cervicitis es una inflamación del cuello uterino que puede ser el resultado de una infección o lesión en esta área, generalmente causada por transmisión sexual. La cervicitis es una condición muy común en mujeres en edad reproductiva, además puede ser sintomática o asintomática. El tratamiento de la cervicitis tiene como objetivo abordar las causas ocultas o no visibles en primera instancia. La cervicitis se transmite de una pareja a otra durante las relaciones sexuales.
La clamidia y la gonorrea son Enfermedades de Transmisión Sexual (ETS) que al no ser tratadas pueden generar cervicitis. Algunos de los síntomas más comunes de la cervicitis suelen ser las alteraciones en el flujo vaginal, presencia de sangrado entre períodos menstruales y dolor durante las relaciones sexuales.
El diagnóstico oportuno de la cervicitis es clave dado que al ser una enfermedad silenciosa puede avanzar y generar complicaciones como:
- Endometritis
- Severas consecuencias en gestantes
- Salpingitis
- Enfermedad Pélvica Inflamatoria (EPI)

“La Cervicitis es un padecimiento exclusivamente de las mujeres que se puede presentar en edades tempranas y que ya iniciaron vida sexual incluso hasta la 3a y 4a edad, puede ser infecciosa y estar producida por diversos gérmenes patógenos o "malos" que entran y se desarrollan dentro de la vagina produciendo inflamación y secreción que puede o no ser de mal olor y salir a la parte externa de los genitales, pero también pueden subir al útero y a las trompas de Falopio.”
Cervicitis síntomas
La mayoría de las veces, la cervicitis es asintomática. Sin embargo, los casos que sí presentan síntomas suelen estar relacionados con la presencia de una infección. Los síntomas de cervicitis más comunes suelen ser:
-
![Presencia de sangrado entre períodos menstruales]()
Presencia de sangrado entre períodos menstruales
-
![Enrojecimiento]()
Enrojecimiento
-
![Micciones dolorosas]()
Micciones dolorosas
-
![Aumento del flujo vaginal y mal olor de forma inusual]()
Aumento del flujo vaginal y mal olor de forma inusual
-
![Dolor pélvico crónico]()
Dolor pélvico crónico
-
![Dolor durante las relaciones sexuales]()
Dolor durante las relaciones sexuales
-
![Presencia de sangrado vaginal]()
Presencia de sangrado vaginal posterior a las relaciones sexuales que no es explicado por el período menstrual
Pero, ¿cuándo consultar al ginecólogo?
En general, la presencia de cualquiera de los síntomas descritos anteriormente es razón suficiente para que consultes al médico ginecólogo de tu elección. Todos los síntomas de cervicitis son una señal de alerta ya que si la cervicitis no es diagnosticada a tiempo, las consecuencias médicas pueden ser cada vez peores.
Visita a tu ginecólogo/a cuando:

Flujo vaginal inusual, constante y con mal olor

Sensación de dolor durante las relaciones sexuales

Presencia de sangrados vaginales que no pueden ser explicados por los períodos menstruales

“Sugiero no dejar pasar mucho tiempo una vez que las molestias se presenten y sigan en aumento, es conveniente acudir con su ginecólogo de confianza y NO automedicarse.”
Cervicitis causas
Las causas de cervicitis pueden ser:
-
![Microbianas]()
Microbianas
-
![Virales]()
Virales
-
![Postraumáticas]()
Postraumáticas
Los gérmenes que podrían ser los responsables de la cervicitis son:
-
![El micoplasma]()
El micoplasma
-
![La ureaplasma]()
La ureaplasma
-
![Los folículos pilosos]()
Los folículos pilosos
-
![Enfermedades de Transmisión Sexual]()
Enfermedades de Transmisión Sexual como la gonorrea y la clamidia.
Los virus más comunes que causan cervicitis son:
-
![El Virus del Papiloma Humano - VPH]()
-
![El herpes genital]()
El herpes genital

“Por otro lado, la cervicitis no infecciosa ocurre cuando el epitelio o la capa externa de la cérvix se encuentra inflamada, con o sin sangrado, que es producido por cuerpos extraños, el lubricante de los preservativos, el uso de tampax por periodos prolongados. Tuve un caso de una paciente que se colocó un tampón y se le olvidó sacarlo durante 1 mes, pero días posteriores se ponía otros y los retiraba normalmente. Luego empezó a notar un mal olor y una secreción que iba en aumento hasta que decidió ir a consultarme y sorpresivamente encontré, muy al fondo de la vagina casi cubriendo el Cérvix, el tampón insertado desde hace 1 mes.”
Otras causas de la cervicitis pueden incluir traumatismos durante el parto o alergias a ciertos espermicidas o condones de látex, así como lesiones o inflamación debido al uso de tampones o diafragma vaginal. Además, la cervicitis también puede ser causada por la presencia de implantes como el de la columna uterina que se usa para tratar el prolapso uterino.
¿Cómo se diagnostica la cervicitis?
Para diagnosticar la cervicitis, el ginecólogo obstetra debe realizar un examen clínico macroscópico. Durante el examen, el médico ginecólogo te realizará una prueba de Papanicolaou y un cultivo de fluido vaginal. También, si es necesario, se puede realizar una colposcopia para comprobar la extensión de la lesión por la cervicitis.
¿Qué me puede preguntar el ginecólogo durante la cita médica del diagnóstico de la cervicitis?
Es importante que tengas en cuenta que durante la visita el médico registrará tu historial médico, te preguntará sobre tus hábitos sexuales tales como el número de parejas sexuales que frecuentas, si siempre usas condón o no, qué tipo de anticonceptivo usas, etc. Toda esta información es esencial para cotejar con los resultados de los exámenes de laboratorio y lograr adjudicar el correcto diagnóstico de cervicitis, para luego dar inicio al tratamiento adecuado.

“Para hacer el diagnóstico se le realiza un interrogatorio a la paciente sobre sus molestias, desde ardor exterior o sólo interior, comezón por la salida de la secreción proveniente del cuello del cérvix, tiempo de aparición, si se han automedicado etc. Luego, se hace una exploración armada con espejo vaginal estéril o desechable y se observa minuciosamente el cérvix, el color y la textura que puede ser líquida, viscosa, espesa y hasta con grumos como leche cortada, ¡incluso se puede observar espuma! Luego se toma una muestra y cuando no se identifica el posible germen se le solicita un estudio de laboratorio que se llama Exudado Cérvico Vaginal (al que deberán presentarse sin bañarse, no haber tenido relación sexual y medicación vaginal por lo menos 3 días antes y sin menstruación)”
Tratamiento para la cervicitis
El tratamiento tanto de la cervicitis cronica como de la cervicitis aguda dependerá de las causas que sean identificadas por tu médico.

Si la causa de la cervicitis es una infección o alguna de las Enfermedades de Transmisión Sexual (ETS), se requiere tratamiento. En caso de que la causa sea una ETS, tu pareja también debe recibir tratamiento.
Atención: Se recomienda que tanto tú como tu pareja se abstengan de tener relaciones sexuales mientras estén recibiendo el tratamiento.

Si la cervicitis es de origen microbiano, el médico ginecólogo-obstetra generalmente puede administrar medicamentos orales como antibióticos u óvulos vaginales.

Si se trata de una cervicitis por Virus del Papiloma Humano - VPH, en una etapa temprana se requiere monitoreo simple, pero si progresa se requerirá un tratamiento adicional, como la eliminación con electrodiatermia o cirugía láser. Será necesario tomar medicamentos antivirales.

Si se trata de una cervicitis ocasionada por una lesión durante el parto, no se necesita tratamiento.
Complicaciones de la cervicitis
Si la cervicitis no se detecta a tiempo, puede causar problemas graves. Especialmente si se trata de la cervicitis microbiana o viral, las complicaciones son muy graves. Las complicaciones que están reportadas por origen microbiano son dolor pélvico crónico y absceso de las trompas de Falopio.
El virus del VPH puede provocar lesiones precancerosas a largo plazo, mientras que las infecciones microbianas (clamidia, gonorrea, etc.), en caso de ser crónicas, pueden continuar afectando hasta las trompas de falopio o dentro del útero y causar infertilidad, o incluso esterilidad.

“Las consecuencias de la cervicitis son peores aún en el embarazo ya que pueden causar la ruptura de las membranas que contienen el líquido amniótico (la fuente).”
Otras complicaciones y consecuencias graves de la cervicitis no tratada son:
- Endometritis
- Severas consecuencias en gestantes
- Salpingitis
- Enfermedad Pélvica Inflamatoria (EPI)
Costo del tratamiento para la cervicitis
El costo del tratamiento para la cervicitis debe incluir una visita al médico ginecólogo, un examen clínico diagnóstico y los medicamentos que te puedan ser prescritos. Es posible que tu ginecólogo te comente la necesidad de realizar un examen de Papanicolaou y una colposcopia para lograr mayor precisión en el diagnóstico de la cervicitis.
Consulta general por ginecología: $700 MXN a $1.000 MXN

Examen de papanicolau:
Mitos y verdades sobre la cervicitis
Solo debo realizarme el papanicolau si tengo una vida sexual activa y no tengo síntomas de cervicitis
Si bien es cierto que el papanicolau se realiza una vez que has comenzado tu vida sexual, esto no quiere decir que si no eres sexualmente activa no te debas realizar el examen. Los especialistas recomiendan hacerse la prueba en los 3 primeros años después de haber iniciado una vida sexual activa o a partir de los 21 años.
La cervicitis no es una enfermedad grave
La cervicitis es una enfermedad que puede generar serias complicaciones médicas si no es tratada a tiempo. Dependiendo de la causa y del tipo de cervicitis que tengas, las consecuencias pueden variar. Las principales complicaciones son la Enfermedad Pélvica Inflamatoria (EPI), la endometritis, consecuencias graves en gestantes y salpingitis.
No puedo contraer clamidia si no hay penetración durante el coito.
La transmisión de la clamidia se puede dar incluso sin penetración. También es posible que se transmita por el uso de juguetes sexuales, por las manos durante los juegos preliminares o por el sexo oral. También puede transmitirse a los ojos por inoculación y a la boca por contacto.
Si me da clamidia será difícil curarme.
El pronóstico es bastante alentador. El 95% de los pacientes se curan completamente de la clamidia en cuanto se complete el primer régimen de tratamiento, si las instrucciones y la medicación se toman correctamente. En cualquier caso, la clamidia es curable si se detecta a tiempo y mientras no haya tenido tiempo de causar daños más profundos como la cervicitis.
Preguntas frecuentes sobre la cervicitis
Si la cervicitis no es diagnosticada a tiempo, puede durar de meses a años. El tratamiento de la cervicitis varía de acuerdo a su causa médica, así que tu médico ginecólogo determinará el tratamiento más adecuado para combatir la enfermedad una vez se hayan identificado muy bien sus raíces y, así, evitar que el cuadro clínico avance.
La cervicitis aguda se caracteriza por producir síntomas repentinos y severos de forma inmediata, mientras que la cervicitis crónica produce síntomas que pueden ser silenciosos o que pueden extenderse de meses a varios años.
No necesariamente. Un resultado anormal puede indicar la existencia de alguna célula que necesite una mayor atención. Si este es el caso, el ginecólogo recomendará algún estudio complementario que permita establecer un diagnóstico, por ejemplo, la colposcopia.
Para detectar la cervicitis a tiempo, el ginecólogo obstetra debe realizar un examen clínico exhaustivo. Durante el examen, el médico te realizará una prueba de Papanicolaou y un cultivo de fluido vaginal. De ser necesario, se puede realizar una colposcopia para comprobar la extensión de la lesión por la cervicitis.

¿Tienes dudas? Habla con nuestros especialistas
Pregunta de forma anónima Pregunta gratis


Te enviaremos un correo electrónico cuando responda un especialista
Ha ocurrido un error inesperado. Por favor intenta nuevamente.

Envía una pregunta anónima
Moderamos tus preguntas y las enviamos a los especialistas de doctoranytime

Recibe actualizaciones para tu pregunta
Si ingresas tu correo electrónico, te avisaremos cuando un especialista responda a tu pregunta

Revisa las respuestas
Una vez que tu pregunta reciba una respuesta, la publicaremos en las secciones relacionadas de doctoranytime